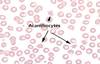
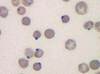

Hematology #1 Flashcards
(30 cards)
All blood tubes have a type of anticoagulant in them.
False
A clean stick is only necessary for routine blood work before anesthesia.
False - a clean stick should be sought after at all times.
WBCs are generally larger than RBCs
True
Platelets are considered a piece of another cell with multiple nuclei
False
WBCs mainly do their job in the blood stream
False
A LTT blood tube is used for a CBC test
True
Blood gases would use a GTT
True
Chemistries and Serology would use a SST for blood collection?
True
Coagulation tests would use a BTT tube
True
What % of plasma is water?
93%
What is the largest of the WBCs?
Neutrophil
Production of blood cells within the bone marrow is called
Hematopoisis
What is the term for a decrease in WBCs
leukopenia
Term for an increase in WBCs
Leukocytosis
What type of WBC would be increased in an animal with allergies?
Eosinophils
Terms used to describe RBC color?
Normochromic, Hyperchromic, Hypochromic, Polychromasia,
Terms to describe RBC size
Anisocytosis, Macrocytes, Microcytes,
Which WBCs are granulocytes?
Neutrophil, Basophil, Eosinophil
What is the difference between plasma and serum?
Plasma contains clotting factors, serum does not.
Which of the WBC is most predominant in cats and dogs?
Neotrophil
What does the acronym IMHA stand for?
Immune-mediated hemolytic anemia
What can cause this condition?
They are a major morphologic feature in dogs with hemangiosarcoma (often accompanied by regenerative anemia).
AKA - Spur cells
What is this called?

Red cells adhere to each other in grape-like clusters because they have been coated with antibodies.
Strongly suggestive of IMHA or erythroparasites
What is this condition and how is is caused?

- Babesia Canis
- Caused by a parasite
- Causes anemia, jaundice, fever, V/D
- Transmitted by many ticks, Dermacentor and Rhipicephalus are examples